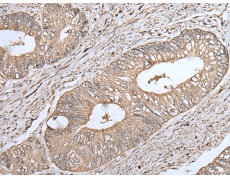
一抗

中文名稱:兔抗UQCRQ多克隆抗體
別 名: QPC; QCR8; QP-C; UQCR7; MC3DN4
抗 原: UQCRQ
儲 存: 冷凍(-20℃)
技術規格
Background:
This gene encodes a ubiquinone-binding protein of low molecular mass. This protein is a small core-associated protein and a subunit of ubiquinol-cytochrome c reductase complex III, which is part of the mitochondrial respiratory chain.
Applications:
ELISA, WB, IHC
Name of antibody:
UQCRQ
Immunogen:
Full length fusion protein
Full name:
ubiquinol-cytochrome c reductase complex III subunit VII
Synonyms:
QPC; QCR8; QP-C; UQCR7; MC3DN4
SwissProt:
O14949
ELISA Recommended dilution:
5000-10000
IHC positive control:
Human liver cancer
IHC Recommend dilution:
40-200
WB Predicted band size:
10 kDa
WB Positive control:
293T,A549,Hela and 231 cell,Human placenta tissue,HEPG2 cell,Human fetal liver tissue lysates
WB Recommended dilution:
500-2000


 購物車
購物車 幫助
幫助
 021-54845833/15800441009
021-54845833/15800441009